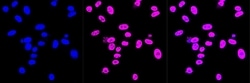
Invitrogen DDX5 Recombinant Rabbit Monoclonal Antibody (23GB3550), Invitrogen

missing translation for 'onlineSavingsMsg'
Learn More
Learn More
Invitrogen™ DDX5 Recombinant Rabbit Monoclonal Antibody (23GB3550), Invitrogen™
Rabbit Recombinant Monoclonal Antibody
Brand: Invitrogen™ MA553405
This item is not returnable.
View return policy
Description
DEAD box proteins, characterized by the conserved motif Asp-Glu-Ala-Asp (DEAD), are putative RNA helicases. They are implicated in a number of cellular processes involving alteration of RNA secondary structure, such as translation initiation, nuclear and mitochondrial splicing, and ribosome and spliceosome assembly. Based on their distribution patterns, some members of this family are believed to be involved in embryogenesis, spermatogenesis, and cellular growth and division. This gene encodes a DEAD box protein, which is a RNA-dependent ATPase, and also a proliferation-associated nuclear antigen, specifically reacting with the simian virus 40 tumor antigen. This gene consists of 13 exons, and alternatively spliced transcripts containing several intron sequences have been detected, but no isoforms encoded by these transcripts have been identified.
Specifications
| DDX5 | |
| Recombinant Monoclonal | |
| Unconjugated | |
| DDX5 | |
| 2600009A06Rik; ATP-dependent RNA helicase DDX5; DDX5; ddx5 gene protein; D-E-A-D (aspartate-glutamate-alanine-aspartate) box polypeptide 5; DEAD (aspartate-glutamate-alanine-aspartate) box polypeptide 5; DEAD (Asp-Glu-Ala-Asp) box helicase 5; DEAD (Asp-Glu-Ala-Asp) box polypeptide 5; DEAD box protein 5; DEAD box RNA helicase DEAD1; DEAD box-5; DEAD/H (Asp-Glu-Ala-Asp/His) box polypeptide 5; DEAD/H (Asp-Glu-Ala-Asp/His) box polypeptide 5 (RNA helicase, 68kD); DEAD-box helicase 5; DKFZp434E109; DKFZp686J01190; G17P1; HELR; Hlr1; HUMP68; mDEAD1; MGC118083; p68; p68 RNA helicase; PCR product with interspecies-compatible primers; probable ATP-dependent RNA helicase DDX5; RNA helicase p68; RP23-247J12.4 | |
| Rabbit | |
| Affinity chromatography | |
| RUO | |
| 13207, 1655, 287765 | |
| -20°C | |
| Liquid |
| Flow Cytometry, Western Blot, Immunocytochemistry | |
| 23GB3550 | |
| PBS with 50% glycerol and 0.02% sodium azide; pH 7.4 | |
| P17844, Q61656 | |
| DDX5 | |
| A synthetic peptide of human DDX5 (1-69AA). | |
| 20 μL | |
| Primary | |
| Human, Mouse, Rat | |
| Antibody | |
| IgG |
Product Content Correction
Your input is important to us. Please complete this form to provide feedback related to the content on this product.
Product Title
Spot an opportunity for improvement?Share a Content Correction